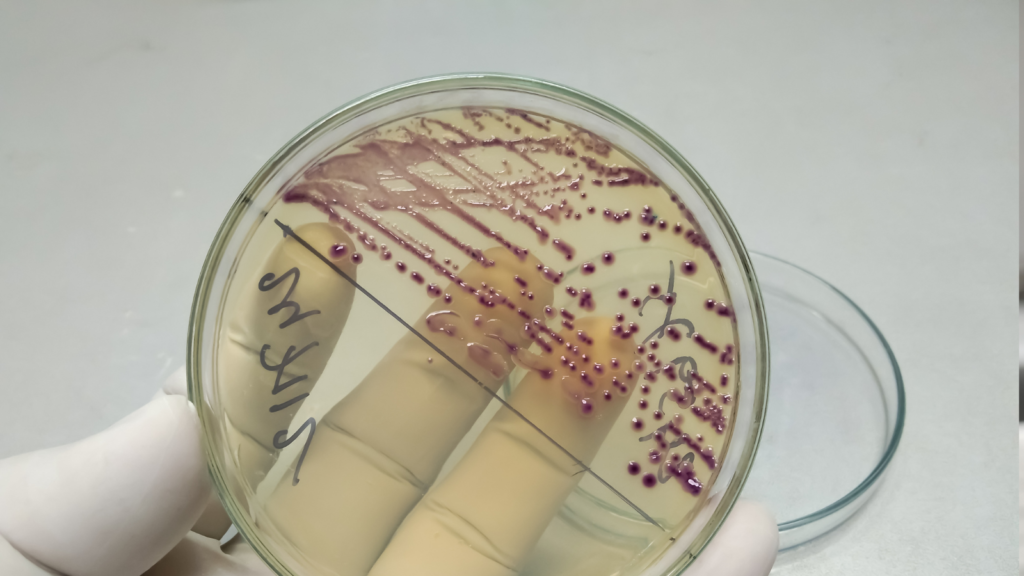

7 Crucial UTI Symptoms You Need to Know Now to Stay Healthy
When it comes to keeping up your wellbeing, it’s imperative to recognize UTI side effects early to anticipate potential complications. A urinary tract contamination (UTI) can be awkward, but it’s as a rule treatable with convenient restorative consideration. Understanding (urinary tract contamination) indications will assist you distinguish the contamination in its early stages and look for suitable care. This web journal will investigate the common indications of a UTI, how to recognize them, and why opportune treatment is basic.
What is a UTI?
A (urinary tract contamination) is an contamination that influences the urinary framework, which incorporates the kidneys, bladder, ureters, and urethra. In spite of the fact that UTIs are more common in ladies, they can influence anybody. Knowing the signs and indications of UTI side effects is vital for anybody who may be at chance of creating one. In most cases, UTIs are treatable with anti-microbials , but left untreated, they can lead to more severe health issues, including kidney damage.
1. Frequent and Urgent Need to Urinate
One of the foremost discernible UTI side effects is the frequent and pressing got to urinate, regularly went with by small to no pee being discharged. This sensation can be overpowering and awkward. On the off chance that you find yourself hurrying to the lavatory regularly but not passing much urine, it may be a sign that your body is battling an disease within the urinary tract. The criticalness of urination combined with inconvenience may be a key (urinary tract contamination) side effect to observe for.
2. Burning Sensation When Urinating

A burning or stinging sensation when urinating is another common (urinary tract contamination)indication. This distress is regularly felt at the conclusion of urination, and it can be very excruciating. This burning sensation happens since the contamination bothers the lining of the urinary tract. On the off chance that you involvement this feeling routinely, it’s critical allude to”>to allude to a healthcare proficient to decide whether it’s due to a UTI or another basic condition.
3. Cloudy or Foul-Smelling Urine
When encountering (urinary tract contamination) side effects, changes within the appearance of your pee are common. Your pee may ended up cloudy, or it may have a solid, unsavory odor. This happens since the contamination can cause the pee to contain discharge, blood, or microbes. On the off chance that you take note that your pee looks cloudy or has an unusual scent, it might be a sign that a UTI is show and needs therapeutic consideration.
4. Blood in Urine
Another genuine (urinary tract contamination)indication is blood within the pee, also known as hematuria. This will extend from minuscule blood that’s as it were perceptible beneath a magnifying lens to unmistakable blood that creates the pee show up pink or ruddy. Blood within the pee may be a solid sign that the disease has influenced the urinary framework, and it requires provoke restorative assessment.
5. Pelvic Pain or Pressure
Pelvic torment or weight can be one of the foremost troubling (urinary tract contamination) indications. This discomfort is regularly felt within the lower midriff or pelvic region. It may be a gloomy throb or a sharp torment, regularly compounded amid urination. In case you involvement determined pelvic torment or weight nearby other indications, it’s vital to look for restorative offer assistance right absent, as this may show that the contamination is influencing the bladder or other parts of the urinary tract.
6. Fatigue and Fever
A UTI can lead to systemic indications such as weariness and fever. Feeling curiously tired or powerless, indeed in the event that you haven’t applied yourself, may be a common side effect when your body is battling an contamination. In more extreme cases, a fever may go with the (urinary tract contamination)side effects. A fever recommends that the contamination may have spread to the kidneys, and critical treatment is fundamental to avoid more genuine complications.

7. Nausea and Vomiting
Whereas queasiness and spewing are less common, they can be extreme UTI side effects in the event that the contamination spreads to the kidneys. Kidney contaminations are much more genuine than bladder contaminations and can cause queasiness, heaving, and torment within the back or side. In case you experience these indications in conjunction with others recorded here, it’s basic to see a specialist instantly. A kidney disease can lead to life-threatening complications in case cleared out untreated.
Why Do UTIs Happen?
Understanding why UTI indications happen is fair as imperative as recognizing them. UTIs are frequently caused by microscopic organisms from the bowel that enter the urinary tract, driving to disease. Ladies are especially helpless due to their shorter urethra, which makes it simpler for microbes to travel to the bladder. Other variables that increment the hazard of creating a UTI incorporate:
- Sexual activity
- Poor hygiene habits
- Holding in urine for long periods
- Certain medical conditions such as diabetes
- Using certain types of birth control (like diaphragms or spermicides)
When to See a Doctor for UTI Symptoms
It’s vital to see a specialist as before long as you suspect UTI side effects. Early intercession can anticipate the contamination from spreading to the kidneys or other parts of the urinary framework. In case you involvement any of the taking after signs, it’s time to look for restorative consideration:
- Blood in your urine
- Severe pelvic pain or pressure
- Fever and chills
- Nausea or vomiting
- Pain that doesn’t go away after urination
A healthcare supplier will perform tests, such as a pee culture, to affirm whether you have got a UTI and decide which microbes are causing the contamination. Based on the comes about, they will endorse the fitting anti-microbials to clear the contamination.
Preventing UTIs
While some individuals may be more prone to developing UTIs, there are several steps you can take to reduce your risk of experiencing UTI symptoms. Here are some tips for prevention:
- Drink plenty of water throughout the day to flush out bacteria from the urinary tract.
- Urinate frequently and do not hold it in for long periods.
- Always wipe from front to back after using the bathroom to avoid transferring bacteria from the anus to the urethra.
- Urinate before and after sexual activity to clear out bacteria that may have entered the urinary tract during intercourse.
- Wear breathable cotton underwear and avoid tight-fitting clothing that can trap moisture.
Conclusion: Stay Vigilant for UTI Symptoms
Recognizing UTI indications early is fundamental for anticipating genuine wellbeing issues. Whether it’s the burning sensation amid urination, cloudy pee, or pelvic torment, knowing the signs of a UTI can assist you take quick activity to ensure your wellbeing. In the event that you involvement any of the indications sketched out in this web journal, do not falter to contact your healthcare supplier for an assessment and suitable treatment. By remaining watchful, you’ll minimize the chance of complications and keep up your generally well-being.
